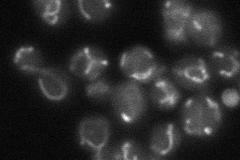

View description
Hydroperoxide and superoxide-radical responsive glutathione-dependent oxidoreductase; mitochondrial matrix protein involved in the synthesis/assembly of iron-sulfur centers; monothiol glutaredoxin subfamily member along with Grx3p and Grx4p
Localization:
Intensity:
Fold change:
Significance:
-
C’ GFP library in SD

mitochondria58.04 -
N' NOP1pr-GFP in SD

mitochondria132.036 -
N' TEF2pr-mCherry in SD

mitochondriaN/A -
N' NATIVEpr-GFP in SD
mitochondria43.6734 -
N' TEF2pr-VC and Cyto-VN in SD

#N/A0 -
C’ GFP library in SD+DTT

mitochondria79.121.36Yes -
C’ GFP library in SD+H2O2

mitochondria49.790.85No -
C’ GFP library in Starvation Media

mitochondria95.121.63Yes -
C’ GFP library on the background of Pup2-DaMP

mitochondria -
C’ GFP library on the background of CCT mutant

mitochondria40.16680.691885No
